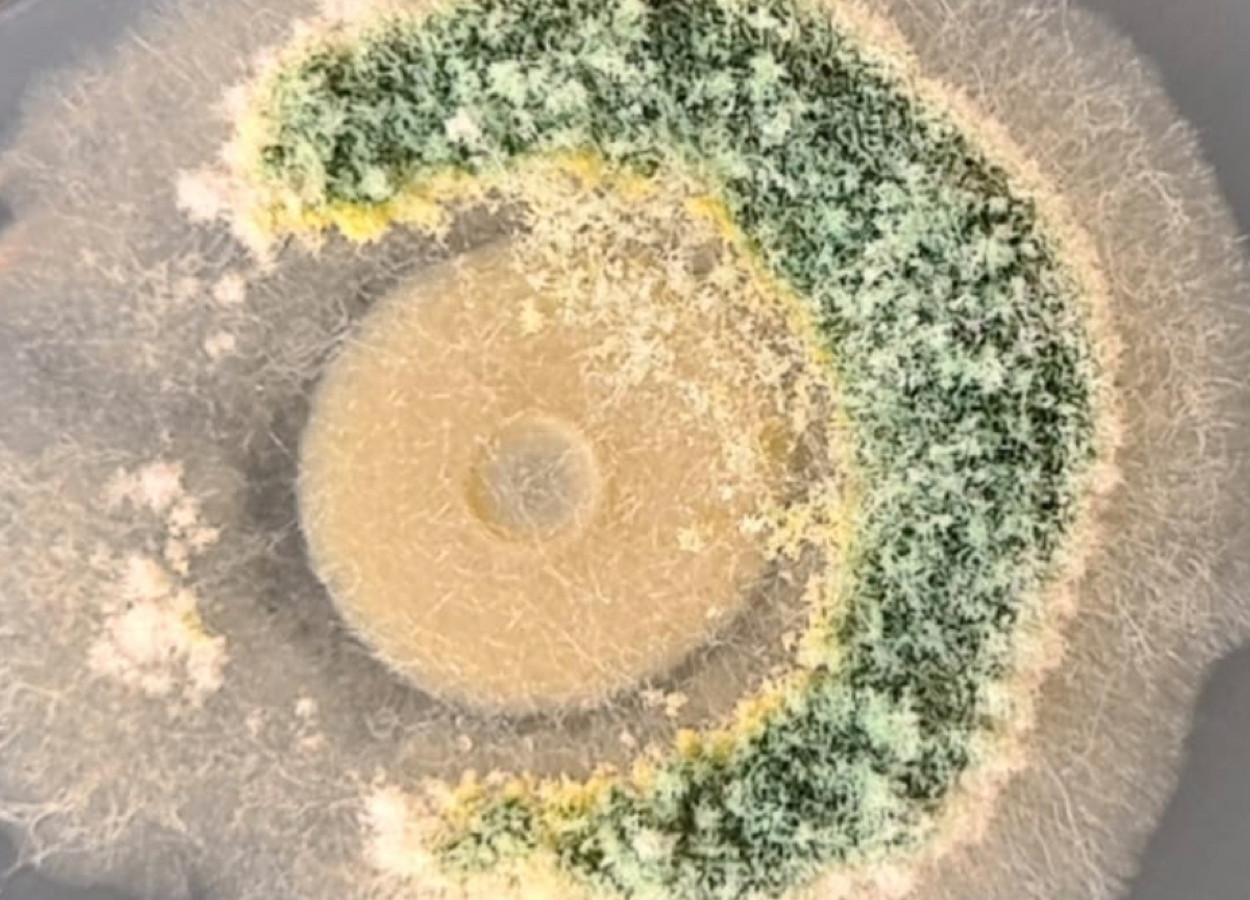
Compatibilidade de agentes biológicos: <i>Bacillus amyloliquefaciens</i>, <i>Trichoderma harzianum</i> e <i>Trichoderma asperellum</i>; produtos com esse tipo de formulação, tendem a ser mais eficientes pois ampliam seus mecanismos de ação - Foto: Sérgio Miguel Mazaro
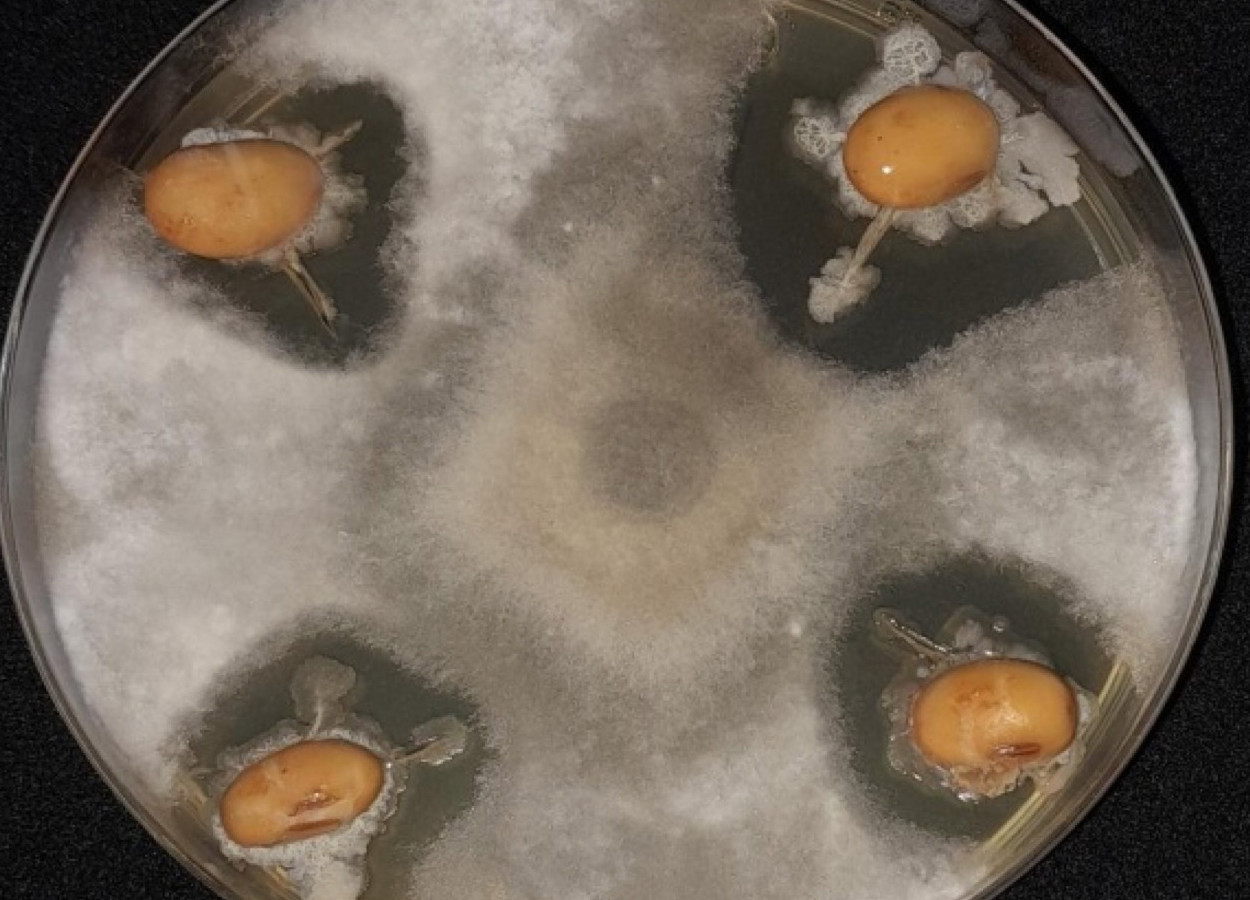
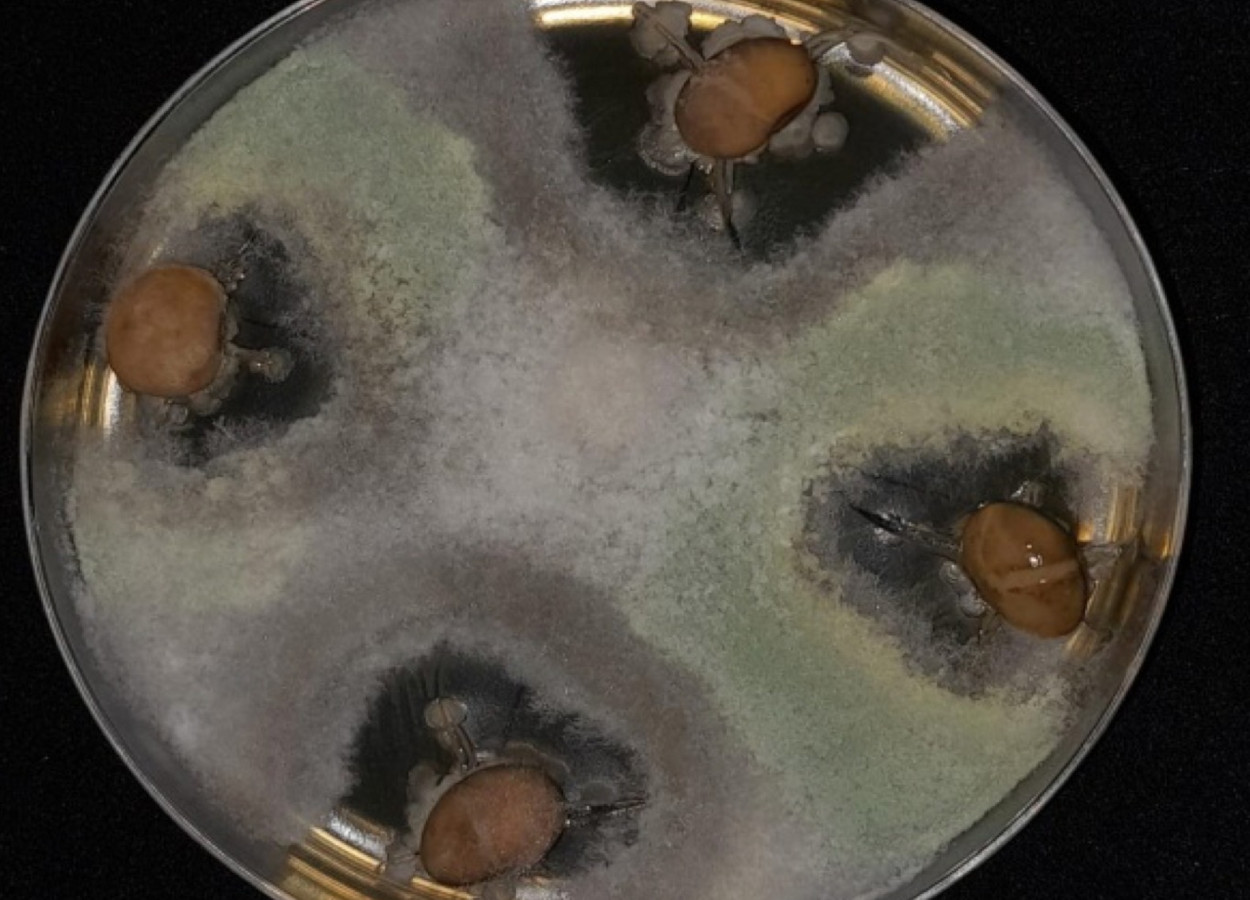
Sinergia de produtos: semente tratada com Bacillus e Trichoderma, onde se colocou um fungo no meio da placa. <i>Trichoderma</i> pela ação de competição foi no encontro do fungo; <i>Bacillus</i> por ser dependente de material vivo, ficou em torno da semente - Foto: Sérgio Miguel Mazaro

Como controlar a broca Diatraea saccharalis em cana-de-açúcar
Diatraea saccharalis tem se destacado nos canaviais; ação conjunta é fundamental

Os bioinsumos posicionados às sementes, junto as demais estratégias químicas e nutricionais, são ferramentas importantes para uma produção agrícola mais eficiente, sustentável e com maior produtividade. Contudo, a escolha dos produtos tem gerado muitas dúvidas e erros, motivo pelo qual o presente artigo foi elaborado. Baseado em pesquisas de laboratório e a campo desenvolvidas últimos anos, visa abordar 7 (sete) pilares práticos a serem considerados para a obtenção de assertividade (usar o que é preciso e que funciona), conforme apresentados abaixo:
Remete a necessidade de conhecer as sementes disponíveis previamente a realização dos tratamentos, quanto aos atributos de qualidade (genética, física, sanitária e fisiológica) e ter a clareza que não existe tratamento ou produto milagroso, mas sim bem posicionado.
Conhecer a qualidade da semente vai oferecer subsídios para trabalhar com ela e a favor dela no posicionamento dos bioinsumos que permitam a máxima expressão do potencial produtivo e reduzindo investimentos desnecessários. As sementes são insumos da propriedade e determinantes para a obtenção de tetos produtivos elevados. Atenção para as patologias e a qualidade fisiológica, pois de forma geral há relação entre o volume de calda e produtos e o período de armazenamento com os atributos de germinação e vigor.
Esse pilar ressalta a importância em conhecer o ativo do bioinsumo, se biológico ou não biológico ou ainda uma combinação de ativos ou produtos, com micronutrientes, aminoácidos, ácidos húmicos e fúlvidos, entre outros.
Se biológico, os pilares elaborados pelo prof. Dr. Sérgio Miguel Mazaro da UTFPR são a referência para a escolha: seleção de produtos / empresas de qualidade; escolha pautada pela especificidade dos isolados / cepas; modalidade de aplicação que atinja o alvo biológico; condições de aplicação e estabilização; compatibilidades com químicos e biológicos; tecnologias envolvidas com relação ao ativo e a formulação e o manejo de sistema. Estes pilares não serão aprofundados, devido à importância da temática e o foco do presente artigo.

Entre os não vivos, a aplicação dos metabólitos, “mostos” nutricionais oriundos de ativos biológicos, aminoácidos, óleos essenciais e extratos (ex.: Ascophillum sp.) são destaques, contribuindo para redução dos patógenos, proteção e nutrição ou em muitos casos como percursores de auxinas e oferecendo condições mais adequada para o estabelecimento e a multiplicação dos ativos Biológicos.
Conhecer o ativo, permite entender os cuidados e o tempo de viabilidade na semente, as compatibilidades com outros produtos e com as sementes. Entendendo que as sementes são vivas e devem receber ativos que condicionem / melhorem a sua qualidade, mas também que sejam veículos para o estabelecimento dos ativos para os problemas de solo. A escolha do ativo deve ser pautada na qualidade da semente, disponibilidade de produtos na região, o investimento, as tecnologias disponíveis nas propriedades, o manejo do sistema de cultivo e as condições ambientais vigentes na aplicação, mas também previstas de ocorrer durante o ciclo.
Entre as estratégias está o tratamento de sementes feito na propriedade antes da semeadura (TS – on farm), podendo envolver produtos químicos, nutricionais e bioinsumos ou apenas alguns por retratamento, como exemplo os inoculantes, com equipamentos mais rudimentares ou mais tecnológicos, via tratabag e aplicação no sulco de semeadura, estratégias usuais para os bioinsumos produzidos "on farm". Apresenta bom desempenho quando bem executado, além de flexibilidade na escolha dos produtos, permitindo trabalhar com bioinsumo que possuem menor "shelf life" (vida de prateleira).
O tratamento industrial de sementes (TSI) feito majoritariamente na indústria é uma excelente estratégia, pois traz grande segurança para os operadores e o agricultor investe seu tempo nas outras demandas da propriedade, pois adquiri a semente com o pacote tecnológico pronto para o uso. O TSI também pode ser realizado na propriedade, por equipamentos adequados e/ou empresas capacitadas.
Atenção para a qualidade da semente e suas capacidades, pois o posicionamento em várias ocasiões, quando realizado sem o conhecimento técnico, pode não entregar os resultados esperados ou ainda pode prejudicar os atributos fisiológicos, além da possibilidade de “queimar” os produtos / empresa.
Relacionado ao conhecimento técnico abordados nos pilares anteriores e entender a tecnologia usada na propriedade. O tempo, após inoculado os tratamentos, que as sementes mantêm sua qualidade fisiológica -- sementes de baixo vigor são mais susceptíveis a perdas de qualidade durante o armazenamento. E também o tempo de viabilidade do ativo do produto de acordo com a formulação deste (ex.: baixa capacidade de armazenamento de Azospirillum sp.).
Ainda, é necessário entender a possibilidade / capacidade de armazenamento na propriedade e as condições climáticas da região / local de armazenamento, destacando a importância de validações e pesquisas, a fim de entender a resposta das espécies e também das cultivares aos tratamentos.
Em geral é o foco / objetivo e onde estão as dúvidas principais de quem utiliza os bioinsumos no sistema (agricultor / cooperativa / sementeira etc.), a preocupação em adquirir as tecnologias / produtos que estão sendo ofertados em abundância no mercado, sendo que, em muitos casos, os critérios de assertividade são desconhecidos ou desconsiderados, prevalecendo um olhar mais comercial ou subjetivo em detrimento do conhecimento técnico e racional.
É o pilar da tomada de decisão em relação ao que vai ser colocado na calda, requer do técnico e do produtor grande expertise, pois muitos erros podem ser cometidos, ao posicionar produtos desnecessários, não compatíveis, com pouca sinergia ou ainda, que não são as prioridades para a propriedade, culminado com investimentos que não vão entregar os resultados esperados em relação a expressão produtiva das plantas e do retorno econômico.
O inoculante é a primeira estratégia a ser pensada, devido aos ganhos produtivos e econômicos que a adição de Bradyrhizobium sp. e do Azospirillum sp. trazem, não necessariamente como a primeira opção no tratamento de sementes, mas com certeza uma opção indispensável.
Segundo momento, pensar a “dor do produtor”, ou seja, problemas que podem ter associados as sementes (qualidade sanitária) e ao solo / propriedade / região, sendo exemplo principais os fungos, bactérias, insetos, nematoides e adversidades climáticas. Os bioinsumos disponíveis podem apresentam sinergias entre as finalidades a que são aplicados -- como exemplos: T. Harzianun (biofungicida e bionematicida); P. fluorescens e P. thivervalensis (biofungicida -- mas também na promoção de crescimento e solubilização); o gênero Bacillus, entre as quais temos -- amyloliquefaciens, velezensis, firmus (com funções de bionematicida, biofungicida, promotores de crescimento, entre outras), mas também o aryabhattai para estresses hídricos, altamente recomendado no sul do país em anos de La Niña; P. lilacinum (bionematicida).
Após estas definições, olhar para as estratégias que melhoram / condicionam a germinação, emergência e o estabelecimento inicial do stand de plantas como biorreguladores e bioestimulantes. Em muitos casos esse posicionamento considera as possibilidades que apresentam sinergia com a dor do produtor, mas também como opções estão os extratos de algas (ex.: Ascophyllum sp.) e vegetais, metabolitos, estes que podem vir associados a aminoácidos e a micronutrientes (Co, Ni, Mn, Mo, S, Zn) -- atenção para o índice salino ser inferior a 30.
Alguns microorganismos ou bioestimulantes podem produzir grande “agressividade” no processo e devem ser utilizados, sem grande sobreposição e com doses recomendadas, por exemplo Bacillus e Azospirillum e Trichoderma, especialmente em sementes com qualidade fisiológica menor. A sequência do posicionamento apresentada, segue uma abordagem genérica e pode ser reorganizada de acordo com a necessidade compreendida a partir da análise dos pilares anteriores. Por fim, a adição de grande número de produtos não é sinônimo de melhores retornos, pois as sementes apresentam limitações em receber produtos e caldas, bem como um olhar para o custo do tratamento deve ser observado, pois nem sempre a melhor ferramenta é a economicamente mais viável.
É a hora de definir quais dos produtos, entre as opções disponíveis, serão utilizados. Para isso, avaliar a compatibilidade entre eles e as formulações e os mecanismos de ação (antibiose, micoparasitismo, competição, indução de resistência), contabilizar a dose e a capacidade da semente em receber. A utilização de protetores de bactérias e também a aplicação dos biológicos junto ou imediatamente após os polímeros, permiti melhores condições para estes nas sementes.
De forma geral, o volume de calda ideal dos produtos químicos, nutricionais, polímeros, protetores e bioinsumos é de 7 a 8 ml/kg de semente, com boa segurança. Contudo aplicações de calda em torno de 10 a 12 ml/kg de semente são utilizadas, mas tendo atenção para a semente apresentar alta qualidade fisiológica. Para tratamentos pré semeadura, como por exemplo o tratabag e sulco o volume de calda recomendado é entre 40 a 50 L/ha.
Logo, é possível perceber que por diferentes motivos não é possível posicionar todos os produtos de interesse e dessa forma, a assertividade é construída com base no conhecimento técnico e científico associado a expertise dos produtores e técnicos responsáveis pelas tomadas de decisão.
Fundamental para o êxito do processo produtivo e do uso dos bioinsumos, especialmente a médio / longo prazo e com estabilidade. Envolve desde estratégias relacionadas a plantabilidade, qualidade do solo, disponibilidade hídrica e de matéria orgânica, entre outros, ou seja, é relevante entender que além de sementes de qualidade, com bons produtos bem posicionados o básico deve ser bem feito.
Além disso, os processos produtivos vão para além dos resultados a curto prazo (na safra) e que o uso dos bioinsumo posicionados nas diferentes culturas -- de inverno e verão -- e nos diferentes momentos / fases fenológicas podem produzir resultados no sistema, contribuindo para os ganhos em produtividade e redução dos custos produtivos ao longo dos anos.
Como exemplo de manejo de sistemas, tem-se a utilização de biofungicidas e bionematicida nas culturas de inverno e entressafra, contribuindo para redução de doenças fúngicas, assumindo a correlação entre a ocorrência de M. javanica, P. brachyurus e H. dihystera com fitopatógenos como Fusarium sp., Phomopsis sp., Rhizoctonia sp. e Macrophomina sp..
O posicionamento assertivo de bioinsumos junto as sementes é uma ferramenta fundamental para o manejo das culturas e contribui para que a agricultura brasileira seja cada vez mais competitiva. Para tanto, conhecer a qualidade da semente e posicionar produtos necessários pensando nas estratégias de inoculação, dor do produtor e bioestumilação e biorregulaçao são importantes e eliminam erros.
Não adianta tratar qualquer semente e colocar qualquer produto na semente, precisa de assertividade, sabendo que o adequado estabelecimento das culturas é a chave para a obtenção de tetos produtivos elevados.
Por André Luiz Radunz, UFFS - Chapecó
** Agradecimento: ao amigo Prof. Sérgio Miguel Mazaro pela parceria, pela revisão do texto e a amizade construída.

Receba por e-mail as últimas notícias sobre agricultura